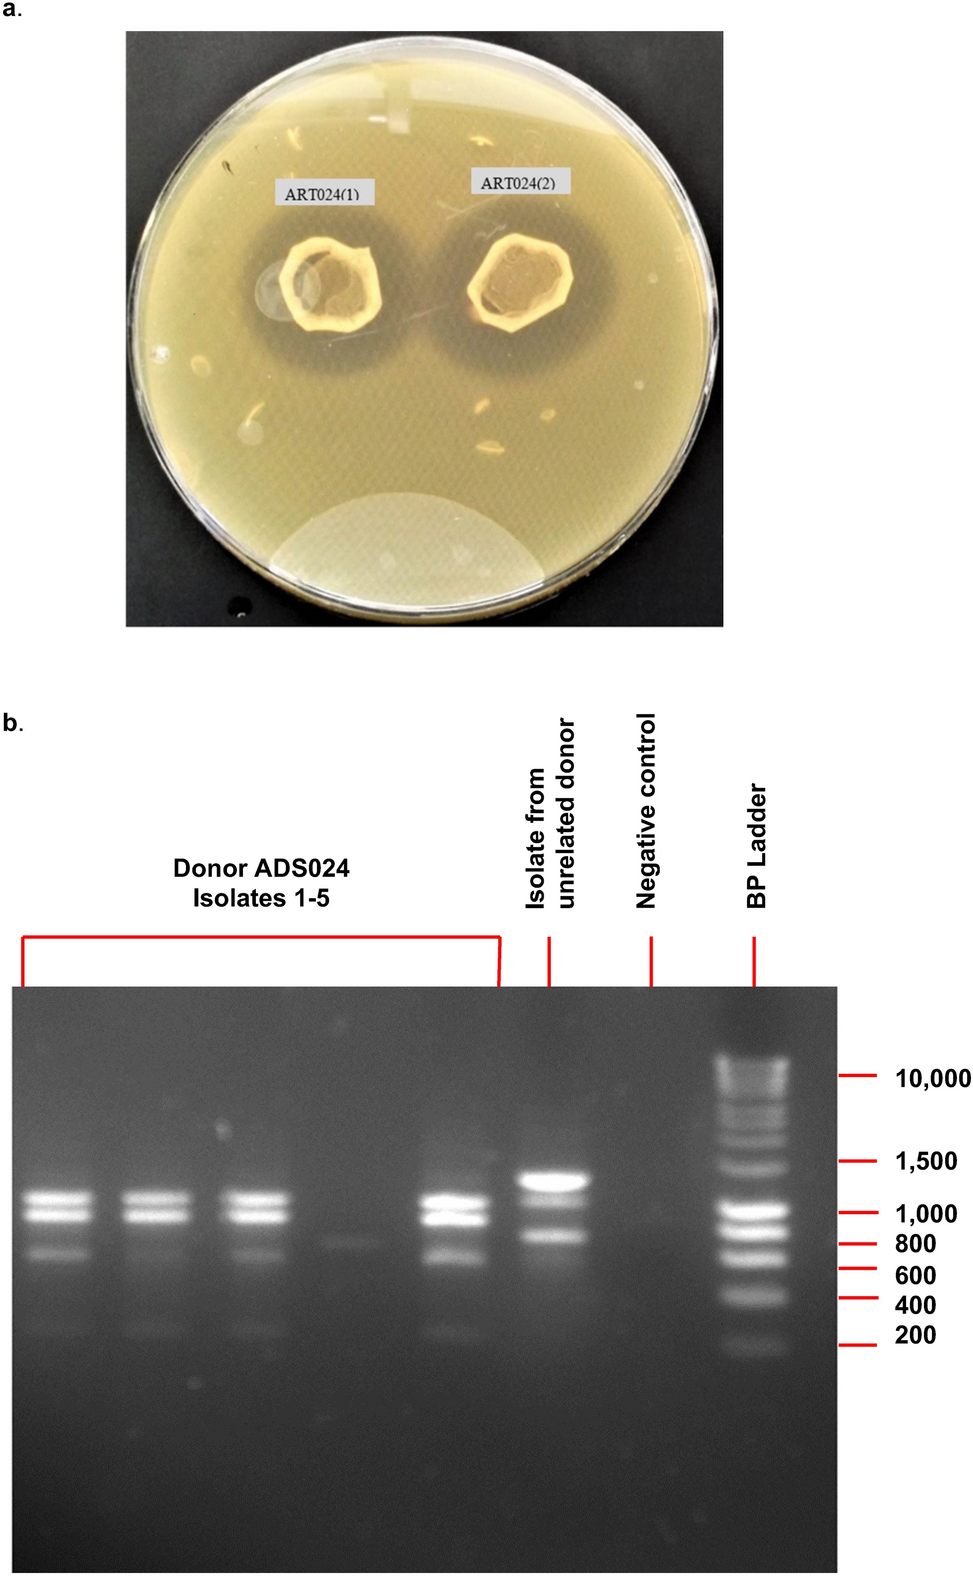
Figure 1

Figure 1
A culture-based screen of fecal samples identified ADS024. (a) Representative isolates from a single healthy human donor (ADS024) demonstrating zones of inhibition in a deferred antagonism assay with C. difficile. (b) Random amplified polymorphic DNA analysis demonstrating that 4 of the 5 isolates belong to the same bacterial strain.
